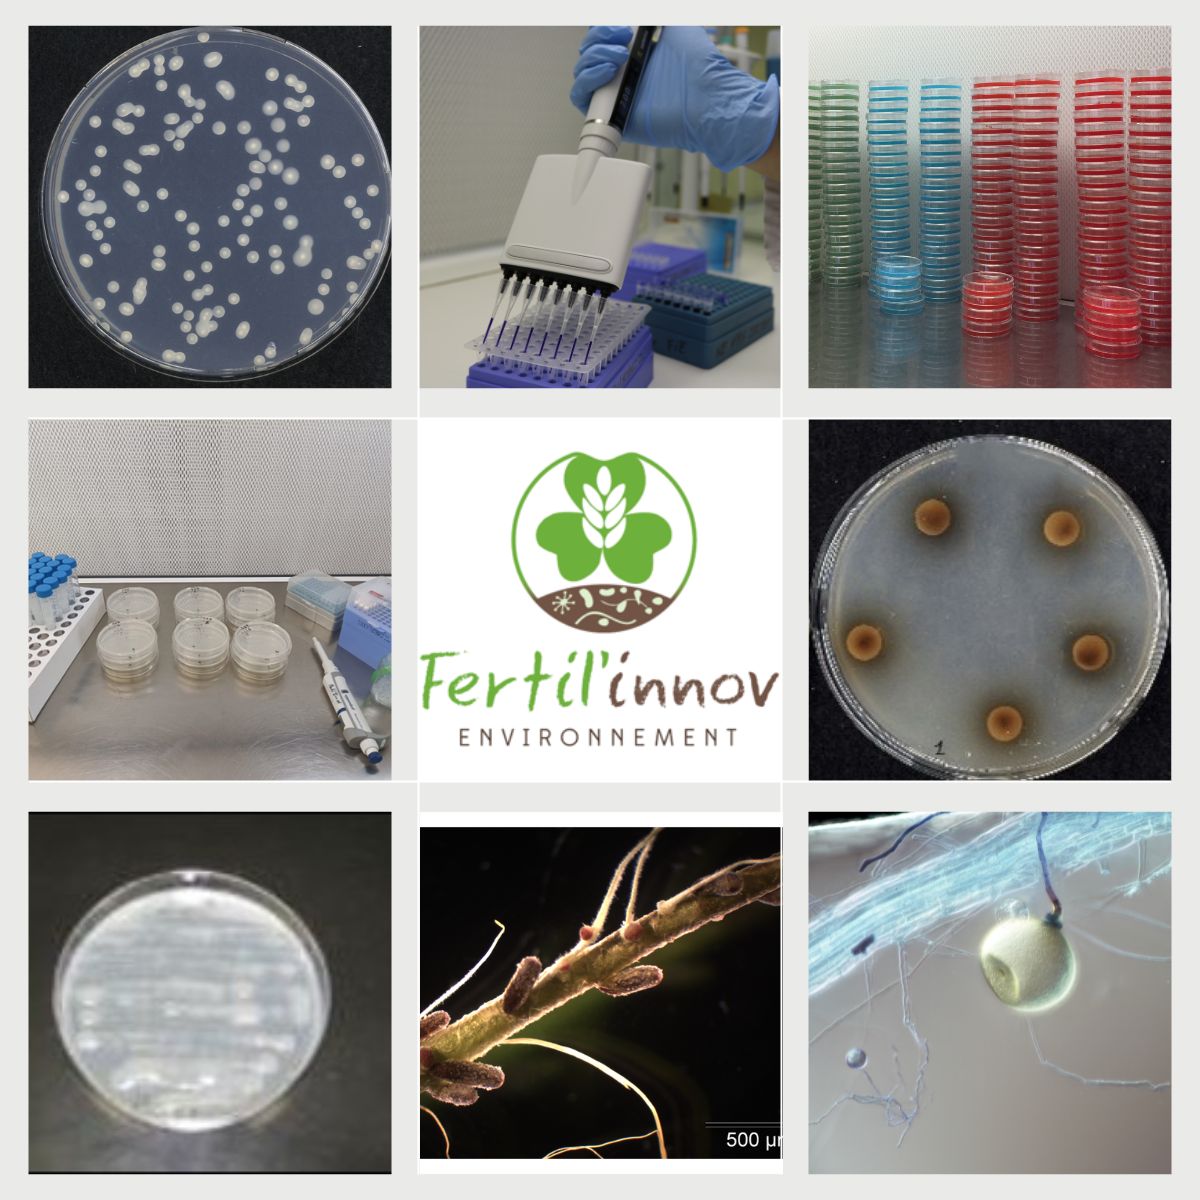
Analyse de biostimulants en laboratoire

Notre CEO partage son expertise sur la microbiologie des sols
Interview exclusive sur SansTransition où Souhir Soussou explique l'importance de l'innovation microbienne.
Écouter l'interview
Chargement
Nos dernières publications et interventions médiatiques.
Interview exclusive sur SansTransition où Souhir Soussou explique l'importance de l'innovation microbienne.
Écouter l'interview Innovation
Innovation
Retour sur notre participation avec CRISALID et le pôle AXELERA autour des enjeux de réhabilitation des sols.
Voir la publication Agriculture
Agriculture
Accompagnement d'ALTIFLORE dans la culture d'Arnica et d'Argousier : symbiose racinaire au cœur de notre expertise.
Voir la publication Recherche
Recherche
Une journée d'essais ensoleillée avec notre équipe et nos partenaires pour le projet de réhabilitation.
Voir la publication Innovation
Innovation
Kick-off meeting du projet Interreg Sudoe pour développer des fertilisants durables à partir de déchets organiques.
Voir la publication Recherche
Recherche
L'importance de quantifier et suivre les microorganismes vivants pour garantir leur performance agronomique.
Voir la publication